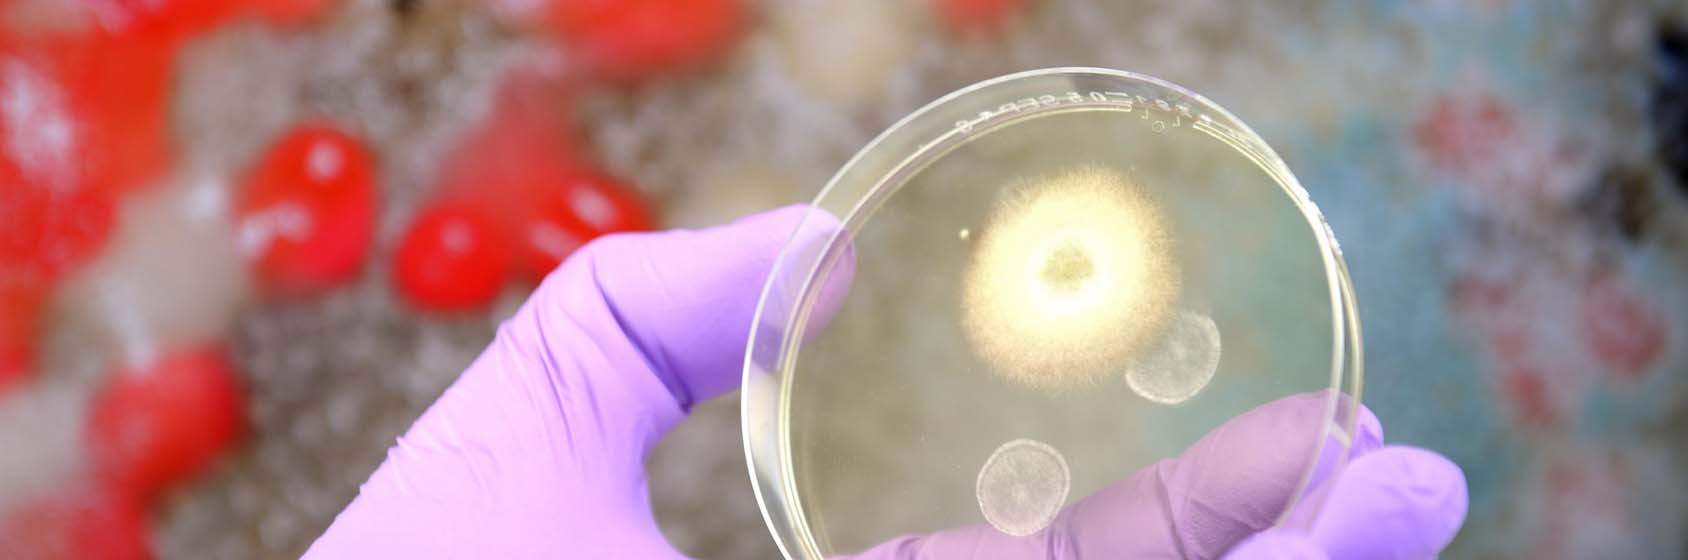

Wir sorgen für Virus- Desinfektionen in der Region
Die Firma Bernd Hellmann Sachverständigenbüro für Feuchte & Schimmelschäden in Gebäuden bietet hochwertige Desinfektionsmittel zur Eigenanwendung an und desinfiziert professionell hochfrequente Bereiche. [weiterlesen ...]
Dienstleistungen
- Infinity- Care (Preis auf Anfrage)
- Desinfektion vor Ort (Preis auf Anfrage)
- Feinreinigung vor Ort (Preis auf Anfrage)
- Luftreiniger (Preis auf Anfrage)

Vor einer fachgerechten Schimmelpilzsanierung muss die Ursache bekannt und behoben sein.

Es ist wichtig, die Luftfeuchtigkeit möglichst niedrig zu halten.
Stichwort "Querlüftung"!

Bauforensik wird im Bereich der Schadensuntersuchungen durch den Sachverständigen angewendet. Durch die IR-Reflexions- und UV-Fluoreszenztechniken kann man Schäden / Schimmel im Baugewerbe sehen, die vorher nicht sichtbar sind.

Als qualifizierter Sachverständiger für Schimmel und Schimmelpilzbeseitigung erstellen wir umfassende Schimmel-Sachverständigengutachten bei Schäden durch Schimmel am Bauwerk.
Erstberatung
ERSTBERATUNG (1 Std.) mit mündlichen Tipps, Ratschlägen und Messung von Feuchtigkeit / Luftfeuchtiggkeit, Taupunkt.
190,00 € *
Jede weitere Stunde wird mit 75,00 € * berechnet.
Fahrtkosten im Bereich Solingen von 12,00 € *. Andere Orte 0,82 Cent * pro km für An und Abfahrt, bzw. nach tel. Vereinbarung
Kurzbericht
ab 57,00 € *
Schriftliche Bewertung
ab 33,00 € * je nach Umfang.
Datenlogger
Aufstellung und Auswertung von Datenloggern (Temperatur/Feuchtigkeit)
Pro Woche 53,00 € *
Verleih / Verkauf von Infrarot Trocknungsplatten, Kondenstrockner auf Anfrage
Verkauf von Thermo / Hygrometer (Messung von Temperatur und Luftfeuchtigkeit) 20,00 € *
* inkl. MwSt
Wir sind Mitglied
im Bundesverbandes Schimmelpilzsanierung e. V.


Mit unseren modernen Diagnoseverfahren und unserer langjährigen Erfahrung gehen wir den versteckten Mängeln (wie z.B. Wärmebrücken) auf den Grund.

Das kleine Labor direkt für die Baustelle.
Mycometer® ist eine zeitgemäße, präzise Analysemethode, mit der vor Ort quantitative Messungen von mikrobiellem Befall durchgeführt werden können. [weiter...]